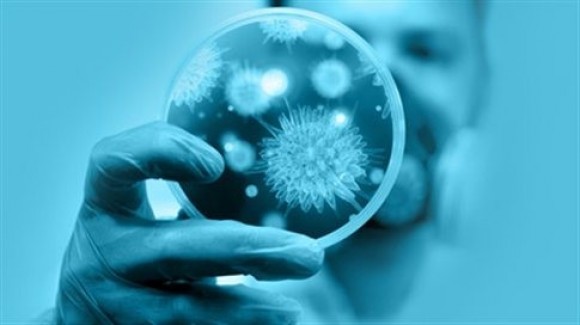
Αυτοάνοσα: Αίτια και εξέλιξη των νοσημάτων

Η εκπληκτική “κοιλάδα των κρίνων”!
Στην κεντρική ακτή της Καλιφόρνιας η οροσειρά Santa Lucia δημιουργεί ένα μεγάλο φαράγγι ανάμεσα στα βουνά, δύσκολο στην πρόσβαση αλλά παρόλα αυτά εκπληκτικό στη θέα.
Συνταγή για έναν αυθεντικό κρητικό ντάκο
Από τον Άκη Πετρετζίκη.
Απίστευτο! Αφησαν ελεύθερο το «κτήνος» της Αργολίδας
Απίστευτο! Ελεύθερος με περιοριστικούς όρους αφέθηκε ο πα-τέρας, που κατηγορείται ότι συμμετείχε μαζί με τον φίλο του, στη σεξουαλική κακοποίηση του 12χρονου παιδιού του, στην Αργολίδα. Ο δεύτερος των κατηγορουμένων προφυλακίστηκε και οδηγήθηκε σήμερα στις φυλακές Τριπόλεως. Ο πατέρας του παιδιού και ο 37χρονος φίλος του συνελήφθησαν στις 8 Ιουλίου από αστυνομικούς της υποδιεύθυνσης ανηλίκων Αττικής, μετά από καταγγελία της μητέρας του 12χρονου, η οποία ζει στην Αθήνα. Ο 35χρονος πατέρας αφέθηκε ελεύθερος, λόγω επίσης αναπηρίας, με περιοριστικούς όρους και συγκεκριμένα να μην πλησιάζει σχολεία και παιδικές χαρές και να μην έχει καμία επαφή με το παιδί, απαγόρευση εξόδου από τη χώρα και παρουσία στο αστυνομικό τμήμα της περιοχής του 3 φορές το μήνα.
12 πανέμορφα “άγνωστα” σημεία του πλανήτη!
Ο πλανήτης Γη είναι γεμάτος από μέρη μοναδικής ομορφιάς και σημεία που κόβουν την ανάσα.
Αυτοάνοσα: Αίτια και εξέλιξη των νοσημάτων
Τα αυτοάνοσα αφορούν σε ασθένειες όπου ο ίδιος ο οργανισμός επιτίθεται στους δικούς του ιστούς και όργανα.
Για ρίγανη στον Αίνο με την Ορειβατική Λέσχη
Στις 17-7-16 θα πραγματοποιήσουμε το μάζεμα ρίγανης, αντί για τις 24/7.
Aγνώριστος o Χάρισον Φορντ
Στην Ισπανία βρέθηκε για διακοπές ο Χάρισον Φορντ, συνοδευόμενος από τη σύζυγο του.
8 ελληνικές παραλίες στις καλύτερες «μυστικές» παραλίες στην Ευρώπη!
Οι παραλίες είναι το «κλειδί» για αξέχαστες διακοπές, όμως η τέλεια παραλία δεν εντοπίζεται μόνο κατά τύχη.